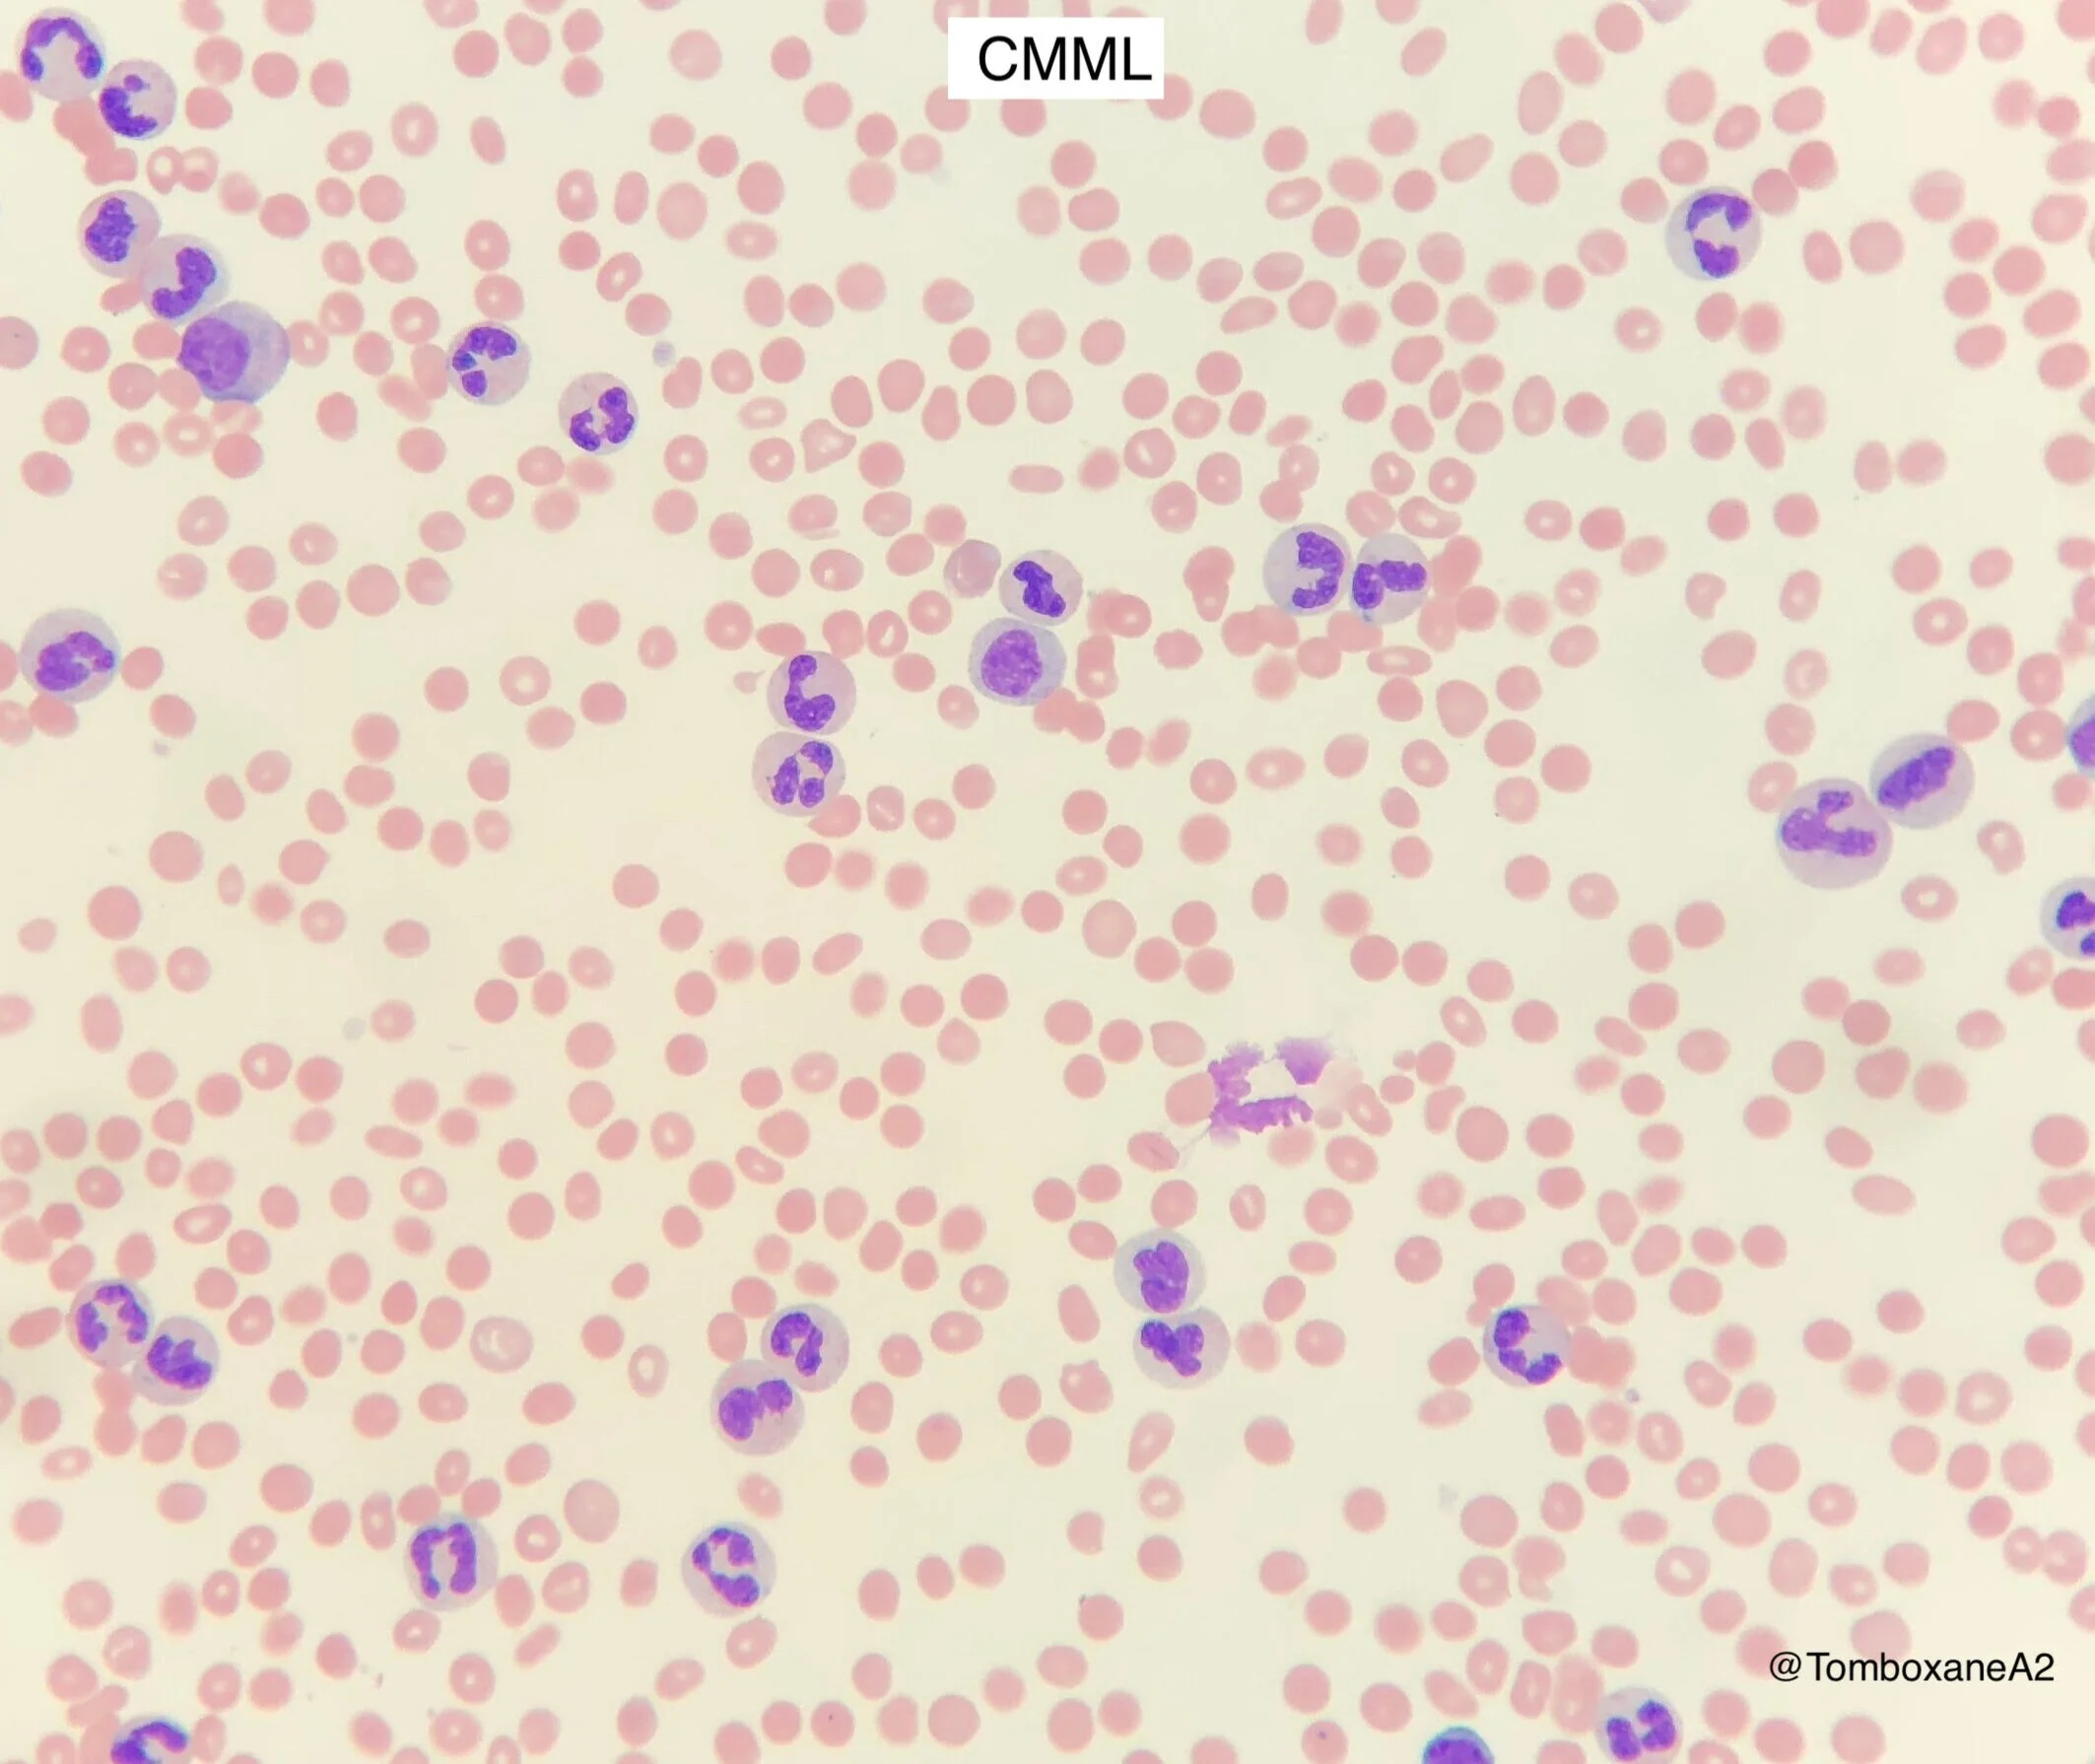

chronic myelomonocytic leukaemia (CMML) (Blood 2017, WHO 2016)
Persistent peripheral blood monocytes >1x10e9/l plus Monocytes >10% of white blood cells on film
N.B. See also MDS
intro
MDS/MPN overlap syndrome
Incidence - 3-4 per million per year in USA & Europe
Median age 72 years old
Male: Female 2:1
Median survival only 20-40 months
Leukaemic transformation in 15-30%
who-HAEM5 diagnostic criteria
Diagnostic Requirements
Prerequisite criteria must be present but:
Monocytosis >1.0: Any one or more supporting criteria must be met
Monocytosis 0.5-1.0: Supporting criteria 1 and 2 must be met
Prerequisite Criteria
Persistent peripheral blood monocytosis (>0.5x10e9/l) AND monocytes >10% of white blood cell count
<20% blasts (myeloblasts, monoblasts and promonocytes) in PB and BM
Not meeting the criteria for CML, Myelofibrosis, PV or ET
Not meeting the criteria for myeloid/lymphoid neoplasms with tyrosine kinase fusions
Supporting Criteria
1.Dysplasia in one or more lineages (can be absent if other criteria are met and cytogenetic abnorm. present)
2. Acquired clonal cytogenetic or molecular abnormality
3. Abnormal partitioning of peripheral blood monocyte subsets with increased classical monocytes (CD14+, CD16-, >95%)
Subtyping
Myelodysplastic CMML (MD-CMML) = WBC <13
Myeloproliferative CMML (MP-CMML) = WBC >13
Subgrouping
CMML-1 = <10% BM and <5% PB blasts
CMML-2 = 10-19% BM and 5-19% PB blasts
clinical features
Two laboratory/clinical phenotypes seen
Myeloproliferative (MP-CMML) - Adverse outcome. RAS pathway mutations often present.
Myelodysplastic (MD-CMML)
Constitutional symptoms, symptomatic cytopenias, splenomegaly
Extramedullary myelomonocytic infiltrates, associated autoimmune/inflammatory disorders.
laboratory features
Blood film:
Persistent monocytosis (>1x10e9/l) / Monocytes >10% of peripheral blood white cells
Often moderate thrombocytopenia with anisocytosis
Normo- or macro-cytic anaemia
Monocytes generally mature and normal looking but abnormal monocytes may be present
Neutropenia or neutrophilia, in either case dysplastic changes are usually present
Cytogenetic Abnormalities
Detected in approx 30% of patients. Trisomy 8, -Y, Monosomy 7, -7q, Trisomy 21, del(20q)
Molecular
Detected in >90% of patients using molecular panels
TET2, SRSF2, ASXL1, and RAS pathway genes (NRAS, KRAS, CBL)
prognosis / risk stratification
MPN-CMML typically poorer prognosis than MDS-CMML
Median survival ranges from <12 months in older patients, up to 3 years in some subgroups
Several scoring systems available, e.g. CPSS-Mol
Cytogenetic risk:
Low risk - Normal karyotype, loss of Y
Intermediate
High risk - Trisomy 8, Monosomy 7, complex karyotype
Molecular risk:
Poor prognosis with SRSF2 or ASXL1 mutation.
TET2 mutation no prognostic signif
management
Supportive Care
Blood product support
Erythropoeitin-stimulating agents (ESAs) - may achieve transfusion independence in 30% of patients
?Thrombopoietin (TPO) receptor agonists (e.g. eltrombopag)? - clinical trials
Infection prophylaxis
Cytoreduction
Hydroxycarbamide for leukocytosis, constitutional symptoms, splenomegaly, EM haematopoeisis
Does not improve overall survival
Hypomethylation
Azacitidine NICE approved for CMML-2
Response rates 30-60% (CR <15%)
Allogeneic stem cell transplant
Potentially curative option for young/fit enough patients
Approx 30% post-transplant survival after a few years
Deaths equally due to treatment-related complications as from disease relapse
Emerging / Non-NICE approved therapies
Lenzilumab - Anti GM-CSF. Promising results in combo w/ Azacitidine (PREACH-M 2024)